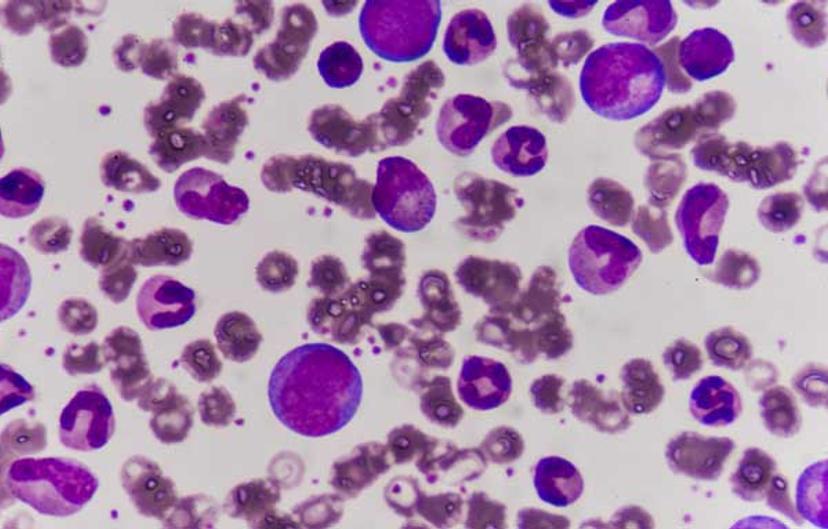

10 Scientists Leading the Fight Against Cancer
SelectScience celebrates scientists at the forefront of cancer research, from liquid biopsies through cancer stem cells to drug delivery innovations
2 Feb 2018
Editorial article
Sunday, February 4, marks the internationally recognized ‘World Cancer Day’, an opportunity for people worldwide to raise awareness and unite in the battle against cancer. These 10 scientists, from across the globe, employ diverse technologies such as live-cell imaging, optical methods, MRI, sequencing, among others, all leading to the same destination – to emerge as winners in the tough fight against the disease. We salute their efforts.
1. Researchers Deplete Cancer Stem Cells to Fight Recurring Brain Tumours
Dr. Raffaella Spina, of Case Western Reserve University, focuses her research on tackling glioblastoma multiforme, an aggressive stage IV brain cancer associated with poor patient outcome. Dr. Spina and colleagues investigate controlling the fate of stem cells (SCs) responsible for propagating these tumors, such as forcing differentiation into non-cancerous astroglial progeny. Their most recent research also involved disruption of the MCT-4 transporter, compromising SC survival and tumor proliferation as a result. Read more

2. How Retrospective Genetic Studies at NIH Are Providing Answers for the Future of Cancer
Genetic mutations and genomic instability are at the core of tumor development. If we can recognize patterns in patient populations that allow us to identify driver mutations, then we can use this information to develop novel therapeutics. Dr. Stephen Chanock, Director of Cancer Epidemiology and Genetics at the U.S National Cancer Institute, NIH, conducts large-scale, retrospective, genome-wide sequencing studies with an overarching goal of mapping susceptibility alleles in primary and metastatic cancers. Read our exclusive Q & A with Dr. Chanock.

3. Detecting Genetic Mutations in Bladder Cancer Patients Using Droplet Digital PCR
With technological advances, the ability to detect circulating tumor DNA in so-called ‘liquid biopsies’ has become possible. Watch this video interview with Emil Christensen, a Ph.D. student from Aarhus University, Denmark, in which he discusses the value of using blood and urine biopsies for predicting the metastatic potential of non-invasive primary bladder cancers, by assessing the quantity and type of genetic mutations in sample fragments. Watch the video

Live-cell imaging is a powerful platform for basic and translational research. Using this technology we can further our understanding of important sub-cellular processes and interactions. Fiorella Magani, of Miami University, utilizes fluorescent labeling in real time to understand the molecular basis of castrate-resistant prostate cancer (CRPC). Read this article to find out more about her specific research into splice variants of the androgen receptor, often upregulated in CRPC.

5. Advances in CAR T Therapy: Reprogramming Patient Cells to Treat Cancer
CAR T, chimeric antigen receptor modified T cell therapy, is an innovative approach in treating cancer, that involves genetic reprogramming of patient immune cells to both recognize and attack cancerous B cells. Read this SelectScience interview with Dr, Richard Jones, of Beckman Coulter, to find out more about the promise of CAR T in treating advanced stage disease.
6. New Optical Method “Cuts” and Examines Cancer Biopsies During Surgery
Surgical tumor resection is a key component of cancer therapy for many patients. However, it is important that, where possible, the surgeon excises the tumor with an appropriate margin to ensure no cells are left behind. Dr. Quincey Brown, of Tulane University, and colleagues, have developed novel optical approaches for prostate cancers that will prevent damage to adjacent structures and reduce the likelihood of surgical spill which often encourages recurrence. Read this SelectScience interview with Dr. Brown to find out more.

7. Dr. Maria Lambros; In vivo imaging to Optimize of Liposome-Mediated Drug Delivery in Cancer
Honing drug delivery to target cancer cells exclusively, is a hugely important area of cancer research. Not only does it improve drug efficacy, but also reduces toxicity to non-cancerous tissues. In an interview with Dr. Maria Lambros, SelectScience finds out more about her work with liposome-encapsulated drugs with live in vivo imaging for kinetic analysis.

8. A 3-Dimensional ‘Google Earth’ Style Map for Tumors
Dr. Josaphine Bunch, of the National Physics Laboratory, London, employs a combination of mass spectrometry techniques to map tumors at the gross and molecular level, in 3D. This technology can also be used to differentiate tumor from non-tumor tissue and will enable us to understand more of the molecular and metabolic basis of cancers for delivering targeted therapy. Read the interview

9. 3D Bioengineered Brains – a New Approach to Personalized Cancer Therapy
In pre-clinical trials, it is vital to analyze drugs in cancer models that most accurately represent the disease in humans. Dr. Min Tang-Schomer is working at the forefront of the tissue bio-engineering field, having developed brain-mimicking tissue that models grey and white matter in composite, with electrophysiological features. Read this article to find out about her current research that involves developing brain models derived from patient-extracted cells for a personalized medicine approach.

Epigenetic regulation of the genome is equally important as the information within our DNA. In this interview, cancer researchers from the MD Anderson Cancer Center, Dr. Sonal Gupta and Dr. Sammy Ferri-Borgogno, give SelectScience an insight into their work on epigenetic regulators in pancreatic cancer, one of the most aggressive cancer diagnoses.
